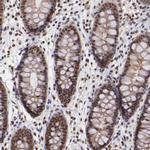
TRF2 Antibody in Immunohistochemistry (Paraffin) (IHC (P))

Search
Invitrogen
TRF2 Polyclonal Antibody
{{$productOrderCtrl.translations['antibody.pdp.commerceCard.promotion.promotions']}}
{{$productOrderCtrl.translations['antibody.pdp.commerceCard.promotion.viewpromo']}}
{{$productOrderCtrl.translations['antibody.pdp.commerceCard.promotion.promocode']}}: {{promo.promoCode}} {{promo.promoTitle}} {{promo.promoDescription}}. {{$productOrderCtrl.translations['antibody.pdp.commerceCard.promotion.learnmore']}}
图: 1 / 5
TRF2 Antibody (PA5-110658) in IHC (P)

产品信息
PA5-110658
种属反应
宿主/亚型
分类
类型
抗原
偶联物
形式
浓度
规格
纯化类型
保存液
内含物
保存条件
运输条件
RRID
产品详细信息
Immunogen sequence: DIMQALLVRP LGKEHTVSRL LRVMQCLSRI EEGENLDCSF DMEAELTPLE SAINVLEMIK TEFTLTEAVV ESSRKLVKEA AVIICIKNKE FEKASKILKK HMSKDPTTQK LRNDLLNIIR EKNLAHPVIQ NF
Highest antigen sequence indentity to the following orthologs: Rat - 95%, Mouse - 96%.
靶标信息
TRF2 is a ubiquitously expressed protein that is implicated in the control of telomere length. TRF2, like TRF1 contains a Myb-related DNA binding motif. It binds to duplex TTAGGG repeats and is localized to all human telomeres in metaphase chromosomes. TRF2 is thought to protect chromosome ends by maintaining the correct structure at telomere termini. The use of mutant forms of TRF2 has implicated a role for TRF2 in the prevention of senescence in primary human cells. Recently, it has been shown that inhibition of TRF2 resulted in apoptosis in a subset of mammalian cell types.
仅用于科研。不用于诊断过程。未经明确授权不得转售。
篇参考文献 (0)
生物信息学
蛋白别名: Telomeric DNA-binding protein; telomeric protein; telomeric repeat binding protein 2; Telomeric repeat-binding factor 2; TTAGGG repeat-binding factor 2
基因别名: TERF2; TRBF2; TRF2
UniProt ID: (Human) Q15554
Entrez Gene ID: (Human) 7014




